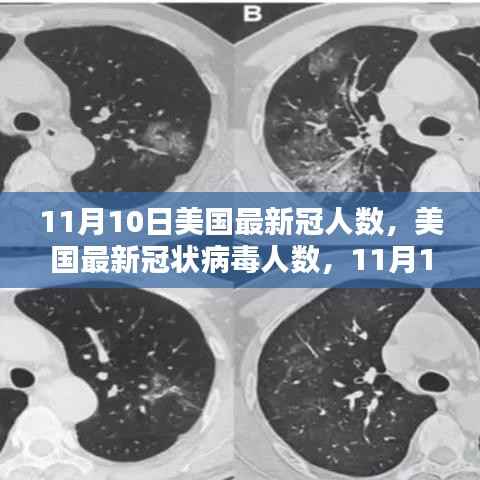
美国最新冠状病毒人数,11月10日的回顾与影响分析

随着季节的更迭,时间的沙漏无情地流淌着,一场全球性的挑战仍在继续,本文旨在探讨美国于XXXX年11月10日的最新冠状病毒人数,回顾其背景、重要事件、影响以及在特定领域或时代中的地位,让我们一起走进这个充满挑战与希望的时刻。
背景概述
自XXXX年底以来,新冠病毒在全球范围内爆发,迅速成为一场前所未有的全球大流行病,在这场疫情中,美国成为受影响最严重的国家之一,随着时间的推移,疫情不断蔓延,病例数量不断攀升,给美国社会带来了前所未有的挑战和考验。
重要事件回顾
XXXX年11月,美国疫情形势依然严峻,随着冬季的到来,疫情的蔓延速度进一步加快,以下是当月的重要事件回顾:
1、新增病例数不断攀升:随着疫情的加剧,美国每日新增病例数持续上升,全国各州纷纷加强防疫措施,但疫情形势依然严峻。
2、疫苗研发和分发:在抗击疫情的过程中,疫苗的研发和分发成为了关键,美国多家制药公司加快了疫苗研发的速度,并在当年年底前开始大规模接种,这为抗击疫情带来了希望之光。
疫情的影响
这场疫情对美国经济和社会产生了深远的影响,以下是一些主要方面:
经济方面:疫情的蔓延导致美国经济遭受重创,企业关闭、失业率上升、供应链中断等问题严重影响了美国的经济增长和发展,随着疫苗的推广和经济的复苏,美国经济逐渐恢复了增长势头。
社会方面:疫情对美国的医疗系统和社会秩序造成了巨大压力,医疗资源紧张、医护人员疲惫不堪等问题凸显出来,疫情对人们的心理健康也造成了严重影响,许多人陷入了恐慌和焦虑之中,社会各界纷纷采取措施应对疫情挑战,共同抗击疫情。
公共卫生方面:这场疫情凸显了公共卫生系统的重要性及其面临的挑战,美国政府和社会各界纷纷加强公共卫生体系建设投入力度提高应对突发卫生事件的能力,同时加强国际合作共同应对全球公共卫生危机。
在特定领域或时代中的地位
新冠疫情无疑成为了这个时代最为重要的事件之一对全球政治经济和社会产生了深远影响改变了人们的生活方式和行为习惯,在美国这场疫情更是给社会带来了前所未有的挑战和考验促使政府和社会各界反思和改进公共卫生体系加强国际合作共同应对全球公共卫生危机,同时这场疫情也加速了科技的发展和应用的进程如远程办公在线教育等新型模式得到了广泛应用改变了人们的生活方式和社会的运行方式,五、结语随着时光的推移新冠疫情的影响逐渐减弱但留下的教训和启示却是长久的,美国在这场疫情中的经历提醒我们公共卫生安全的重要性以及加强国际合作的必要性,让我们携手共进共同应对全球挑战为人类的未来创造更加美好的明天。(完)这便是关于XXXX年XX月XX日美国最新冠状病毒人数的回顾与影响的分析文章希望对您有所启发和帮助。
转载请注明来自宁波市奉化艾尔达铝业有限公司,本文标题:《美国最新冠状病毒人数,11月10日的回顾与影响分析》

蜀ICP备2022005971号-1
还没有评论,来说两句吧...